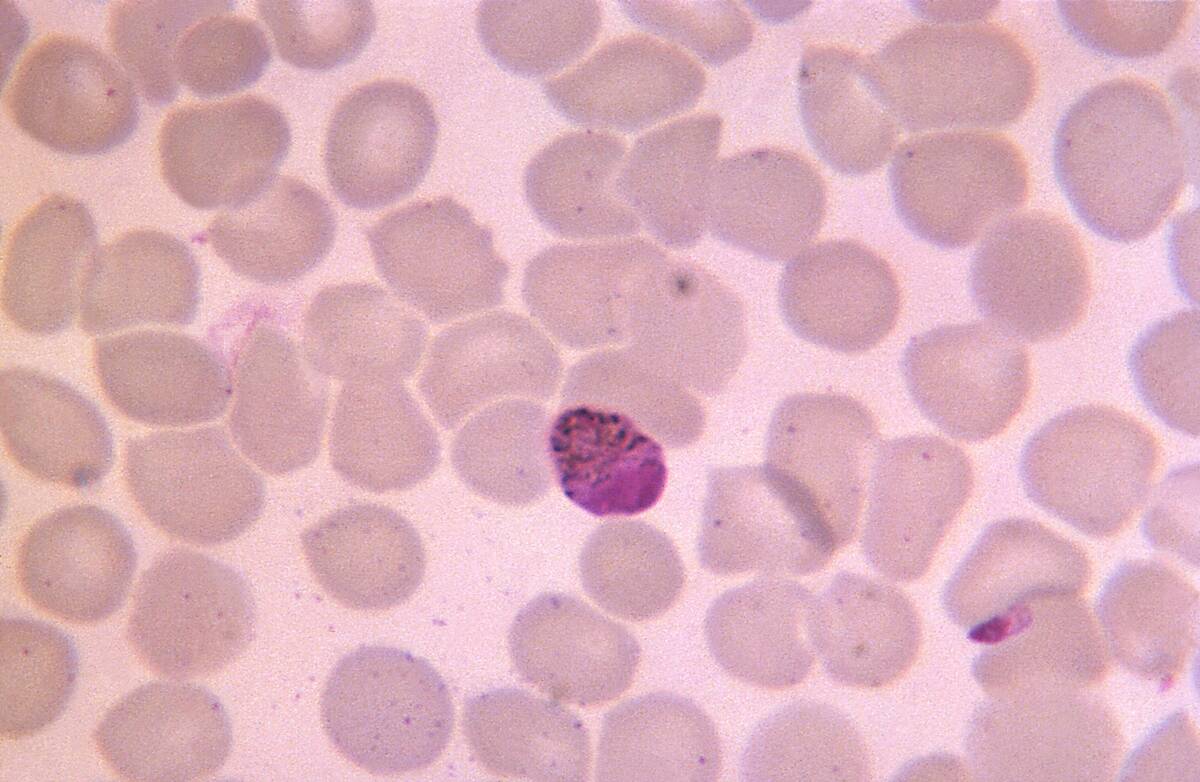
Plasmodium Malariae

How life thrives in sunless ecosystems
Trending Now
Imagine an ecosystem where dawn never breaks and chlorophyll never matters. In 1977, the submersible Alvin found the first hydrothermal vents along the Galápagos Rift, revealing thriving communities that owed nothing to sunlight. Tubeworms, clams, and crabs crowded around hot, mineral-rich springs while bacteria turned chemicals into food. That discovery rewrote textbooks overnight, proving that life can build bustling neighborhoods using geologic energy alone.
Since then, scientists have mapped other “dark food webs” from the deep sea to icy lakes under Antarctica. These places rely on chemosynthesis—microbes using reactions with hydrogen, sulfide, methane, or iron to fix carbon. It’s not a niche footnote: chemosynthetic production shapes seafloor habitats across mid-ocean ridges, subduction margins, and seeps. The rules are familiar—energy in, biomass out—but the power socket is chemical, not solar.
Photosynthesis? Pass—How Chemosynthesis Powers the Party

Chemosynthesis is carbon fixation fueled by redox reactions rather than photons. Sulfur-oxidizing bacteria, for example, use hydrogen sulfide (H2S) and oxygen to generate energy, then capture CO2 through pathways like the Calvin cycle or the reverse TCA cycle. Methanotrophs oxidize methane using methane monooxygenase, turning a greenhouse gas into biomass. Some archaea run the Wood–Ljungdahl pathway, stitching CO2 into organic carbon with remarkable efficiency at low energies.
The energy yield is often lower than photosynthesis, but the payoff is stability where light never reaches. Mix hot, reduced vent fluids with cold, oxygenated seawater and you have an electrochemical buffet. Pair hydrogen as an electron donor with nitrate or oxygen as acceptors, and microbes thrive. It’s modular, too: switch donors to iron(II) or methane, acceptors to sulfate or nitrate, and entire microbial guilds reshuffle without the sun flickering once.
Hydrothermal Vents: Black Smokers, White Smokers, Big Attitudes

Black smokers form when 350–400°C vent fluids loaded with metals hit near-freezing seawater, precipitating fine-grained metal sulfides that look like smoke. These chimneys deposit minerals like pyrite and chalcopyrite. White smokers are cooler and lighter in chemistry, often rich in barium, calcium, and silica, building paler towers. Both rise along spreading centers such as the East Pacific Rise and the Mid-Atlantic Ridge, piping chemistry from Earth’s crust right into biology’s lap.
Around these jets, life piles in fast. On the Pacific’s East Pacific Rise, giant tubeworms (Riftia pachyptila) cluster in dense thickets, while at Mid-Atlantic sites, swarms of shrimp like Rimicaris exoculata dominate. Despite scalding vent fluids, ambient seawater is about 2°C, so animals occupy narrow mixing zones where temperatures and toxins are tolerable. That boundary, just centimeters wide, hosts microbial mats that turn sulfide and hydrogen into the base of the food web.
Cold Seeps: Slow Leaks, Steady Feasts

Cold seeps leak methane, sulfide, and other hydrocarbons from sediments at temperatures close to ambient seawater. They dot continental margins like the Gulf of Mexico and Cascadia. The star reaction is the anaerobic oxidation of methane (AOM), where methane-consuming archaea (ANME) partner with sulfate-reducing bacteria to turn CH4 and sulfate into bicarbonate and sulfide. The bicarbonate can precipitate as carbonate rock, literally cementing the ecosystem in place.
Macrofauna move in for the long haul.
Tubeworms such as Lamellibrachia form gardens that can persist for centuries, and Bathymodiolus mussels host methane- or sulfur-oxidizing symbionts. Seeps also grow microbial mats and carbonates that reshape the seafloor. With a slow but reliable energy supply, communities assemble methodically—less fireworks than hydrothermal vents, but with immense staying power and striking architecture of chimneys, pavements, and mounds.
Whale Falls: When a Giant Carcass Becomes a Mini-Planet

When a whale dies and sinks, it creates an island of food that can feed life for decades. The feast unfolds in stages: mobile scavengers like hagfish strip soft tissue; enrichment opportunists (worms and crustaceans) colonize leftovers; and finally, the sulfophilic stage emerges as microbes break down lipids in the bones, releasing sulfide that fuels chemosynthetic bacteria. It’s a time-release buffet, with chemistry changing as tissues and fats are consumed.
These discoveries came into focus in the late 1980s off California, where researchers documented entire communities anchored to bones. Osedax worms—dubbed “bone-eaters”—bore into skeletal elements and rely on internal bacteria to digest collagen and lipids. Mussels and clams with chemoautotrophic symbionts sometimes appear, echoing vent and seep partnerships. A single carcass can support hundreds of species over time, turning death into a meticulously scheduled ecological afterparty.
Wood Falls and Bone Gardens: Decomposers’ Delight

Logs that sink to the deep sea create wood-fall habitats, where specialized bivalves like Xylophaga drill and, with the help of symbiotic bacteria, digest cellulose. As they and other microbes chew through the timber, sulfide accumulates, enabling chemosynthetic mats much like miniature seeps. Experiments deploying bundles of wood have shown rapid colonization and succession, with invertebrate diversity peaking as the resource transitions from fresh to heavily worked.
“Bone gardens” extend the theme beyond whales. Osedax species colonize fish and mammal bones, their root-like tissues housing bacteria that break down bone lipids. In lab and field studies since their description in 2003, Osedax have revealed surprising flexibility—settling on a range of vertebrate remains. Together, wood and bone falls knit detrital rain into pockets of chemical energy, seeding chemosynthetic life far from vents and seeps.
Deep Subsurface Biosphere: Microbes Miles Down, Moving Slow

Beneath the seafloor lies a vast, low-energy biosphere of microbes living in sediments and fractured basalt. Integrated Ocean Drilling Program cores suggest cell numbers on the order of 10^29 in subseafloor sediments globally. Many rely on sulfate reduction, methanogenesis, or iron reduction, scraping by on energy trickles from buried organic matter, water–rock reactions, or radiolytic products that split water and feed hydrogen to cells.
Turnover is glacial.
Some subseafloor microbes may divide once in decades to centuries, with measured metabolic rates among the lowest known for life. In basaltic crust aquifers, fluids circulate through cracks, delivering oxidants and reductants that keep sparse communities ticking. It’s not a ghost town—just a city of sleepers, with DNA repair, maintenance, and survival pathways prioritized over growth. Evolution favors patience where every electron is precious.
Subglacial Lakes: Hidden Waters Thriving Under Ice

Antarctica hides liquid lakes beneath hundreds of meters of ice, kept from freezing by pressure and geothermal heat. In 2013, clean-access drilling into Subglacial Lake Whillans revealed active microbial communities—thousands of cells per milliliter—oxidizing ammonium, iron, and sulfur compounds. These microbes fix carbon in darkness, tapping chemical gradients in waters isolated from the surface for thousands of years.
Nearby systems like Subglacial Lake Mercer have shown similar life, captured with stringent contamination controls. The chemistry varies by site, but the theme holds: with tiny inputs of minerals and oxidants, microbes run the show. It’s not a nutrient bonanza; it’s a meticulous budget managed at low temperatures and under immense pressure, yet robust enough to support diverse metabolisms cycling nitrogen, sulfur, and iron beneath a continent of ice.
Caves That Feed Themselves: Sulfidic and Other Chemo Caves

Movile Cave in Romania, discovered in 1986, is sealed from the surface and rich in sulfide, methane, and carbon dioxide. Here, microbes oxidize sulfide and methane to build biomass, supporting an entire invertebrate community with many endemic species. Oxygen is scarce, the air is noxious, and yet life thrives by tapping geology for electrons, not sunlight for photons.
Elsewhere, the Frasassi cave system in Italy hosts sulfur-oxidizing mats, while Mexico’s Cueva de Villa Luz dangles “snottites”—acid-dripping microbial colonies formed by sulfuric acid production. These caves are natural reactors for sulfuric acid speleogenesis, where rock dissolves as microbes work. Animals graze the mats, and the whole scene pulses with chemistry, not greenery, a reminder that caves can mint their own food supplies behind stone curtains.
Brine Pools and Anoxic Basins: The “Pickle Jars” of the Deep

In the Gulf of Mexico, hypersaline brine pools—sometimes five times saltier than seawater—form dense, toxic lakes on the seafloor. Cross the rim and most animals die, but microbial mats flourish at the interfaces where oxygen meets sulfide and methane. One site, nicknamed the “Jacuzzi of Despair,” mesmerized ROV pilots with its vivid brine shoreline and utter hostility to unwary crabs and fish.
The Mediterranean hosts deep hypersaline anoxic basins like L’Atalante and Urania. Their brines are anoxic and often sulfidic, isolating layered communities. Above the brine, stratified chemoclines teem with bacteria and archaea that shuttle electrons between methane, sulfide, and nitrate. Life draws crisp boundaries in these pickle jars, with sharp chemical steps replacing sunlight gradients and setting the stage for exquisite microbial zoning.
Meet the Primary Producers: Bacteria and Archaea Running the Kitchen

The chefs of sunless worlds are bacteria and archaea. Campylobacterota (formerly Epsilonproteobacteria) and Gammaproteobacteria often dominate at vents and seeps, oxidizing sulfide, thiosulfate, or hydrogen and fixing CO2 via the reverse TCA or Calvin cycles. Methanotrophic Gammaproteobacteria (e.g., Methylococcaceae) turn methane into carbon skeletons, while Zetaproteobacteria such as Mariprofundus ferrooxydans build rust-hued mats by oxidizing iron(II) at places like Lō‘ihi Seamount.
Archaea bring metabolic swagger. ANME groups partner with sulfate reducers for anaerobic methane oxidation, and many archaea and bacteria run the Wood–Ljungdahl pathway to fix carbon with minimal ATP. Carbonic anhydrases, RuBisCO variants, and robust respiratory chains knit these pathways together. The result: living factories that package geochemistry into cells, ready for grazers, symbionts, and predators to turn into community.
Symbiosis Superstars: Tube Worms, Mussels, Snails, and Their Live-In Chefs

The giant Pacific tubeworm Riftia pachyptila lacks a mouth and gut as an adult. Instead, a vascular organ called the trophosome houses sulfur-oxidizing bacteria that supply the worm with fixed carbon. Its specialized hemoglobins bind both oxygen and sulfide without being poisoned, delivering these reactants to its symbionts. After volcanic eruptions create new vents, Riftia can grow astonishingly fast—sometimes centimeters per week—turning fresh vent fields into crimson gardens.
Mussels of the genus Bathymodiolus house symbionts in their gills, often maintaining both methane- and sulfur-oxidizing bacteria, allowing dietary flexibility as vent chemistry shifts. In the Indo-Pacific, snails such as Alviniconcha and Ifremeria host endosymbionts in enlarged gill tissues, effectively farming microbes within their bodies. These partnerships allow animals to inhabit chemically intense environments, outsourcing primary production while investing in circulation, housing, and protection for their microbial partners.
Extreme Adaptations: Crushing Pressure, Heat, Acid, and No Oxygen

Deep-sea animals and microbes tune membranes, proteins, and fluids to withstand pressure. Many accumulate piezolytes like TMAO, which stabilize proteins as depth increases, and adjust lipid saturation for flexible, pressure-tolerant membranes. Heat lovers such as the Pompeii worm (Alvinella pompejana) cling to chimney walls where surfaces can reach around 60°C, using bacterial coats and behavior to buffer temperatures while avoiding the 350°C vent fluids inches away.
Acidity and anoxia bring their own hacks. In sulfidic caves, microbes generate sulfuric acid that can drop pH to near battery-acid levels on microbial surfaces, yet mats persist. Vent fauna tolerate metals and sulfide with detox proteins and fluid transport tricks. Many microbes swap oxygen for nitrate or sulfate as terminal electron acceptors, and some store nitrate internally, riding out fluctuating conditions as chemistry whipsaws in the mixing zones.
Food Webs in the Dark: Who Eats Whom When Plants Don’t Exist

Start with microbes fixing carbon from sulfide, methane, or hydrogen; then add grazers like limpets and amphipods that scrape mats. Symbiotic animals shortcut the line by growing their own chefs. Predators tier above: zoarcid fish lurk among tubeworms on Pacific vents, while crabs such as Bythograea thermydron scavenge and hunt. Detritus from the bustle drifts into the deep, linking chemosynthetic islands with the wider deep-sea detrital web.
On Mid-Atlantic vents, shrimp like Rimicaris exoculata farm bacteria in their gill chambers, then harvest the crop—a clever hybrid of grazing and symbiosis.
Octopuses and squat lobsters sometimes cruise through, opportunists in a chemical city. Food chains are compact but intense, with energy cycling locally and fast compared to the background deep sea. Remove the microbes, and the marquee animals vanish; remove the chemistry, and the microbes starve.
Chemical Menu: Hydrogen, Sulfide, Methane, Iron, and Friends

The pantry is redox. Hydrogen (H2) from water–rock reactions powers hydrogenotrophs; sulfide (H2S) feeds sulfur oxidizers; methane (CH4) fuels methanotrophs and ANME consortia; ferrous iron (Fe2+) sustains iron oxidizers; and ammonium (NH4+) supports nitrifiers. Mix in electron acceptors—oxygen where mixing allows, nitrate in low-oxygen pockets, or sulfate in anoxic sediments—and microbes run a suite of metabolisms tuned to local gradients.
Even trace metals set the table. Iron and manganese cycles shape habitats like Lō‘ihi Seamount, where iron-oxidizing mats coat lava. At cold seeps, AOM couples methane to sulfate, often producing carbonate crusts that stabilize sediment. Each element writes a recipe: donors supply electrons, acceptors cash them out, and the difference pays for carbon fixation. It’s chemistry as cuisine, with microbes as master chefs.
How We Find Them: Submersibles, ROVs, and Robot Sleuths

Human-occupied vehicles like Alvin let scientists see and sample vents firsthand, while remotely operated vehicles (ROVs) such as Jason provide dexterous, long-duration work with manipulator arms and precise navigation. Autonomous underwater vehicles (AUVs) like Sentry map terrain with multibeam sonar, sniff temperature and chemistry anomalies, and scout new targets efficiently before ROVs move in.
On the sensor side, CTDs and methane detectors flag plumes; in situ mass spectrometers and voltammetric microelectrodes read fluid chemistry; and seafloor observatories (e.g., Ocean Networks Canada) stream real-time data. Towed cameras trail the ship; heat flow probes and magnetotellurics sketch geology. Put it together, and the toolkit triangulates life’s chemical footprints even in pitch-black, high-pressure sprawl.
Why It Matters: Carbon, Methane, and the Planet’s Big Biogeochemical Loops

Chemosynthetic microbes are serious climate accountants. At seeps, anaerobic methane oxidation can intercept vast amounts of methane before it reaches the ocean, forming carbonate rock in the process. Sulfur-oxidizers and reducers shuffle electrons through sulfur compounds, linking to iron and nitrogen cycles. Even when local, these reactions reverberate globally by modulating greenhouse gases and mineral formation at the seabed.
Dark production also feeds higher trophic levels and redistributes elements via food webs and detritus. When carbonate mounds grow or sulfide minerals precipitate, they archive chemistry in stone, letting geologists read past fluxes. Understanding these loops clarifies how Earth’s interior and oceans talk to the atmosphere. The more we know about sunless metabolisms, the better we can forecast carbon and methane pathways in a changing climate.
From Earth to Outer Space: What These Ecosystems Teach Us About Alien Oceans

Alkaline vents like Lost City are prime analogs for icy-moon oceans. Cassini detected molecular hydrogen, salts, and organic compounds in Enceladus’s plumes, hinting at water–rock reactions similar to serpentinization. That sets the table for hydrogen-fueled chemosynthesis beneath kilometers of ice. Europa’s oxidants, generated by surface radiation and potentially mixed downward, could play the role of electron acceptors.
These worlds don’t need sunlight if they have rock, water, and gradients. Dark food webs on Earth show how microbes stitch carbon from CO2 using H2, sulfide, or methane, then scaffold animal communities. Robotic missions now carry life-detection tools designed with vents and seeps in mind—chasing redox “food” and biosignature textures that Earth’s sunless ecosystems taught us to recognize.
Microbial Soap Operas: Viruses, Predators, and Gene Swaps in the Dark
Microbes don’t just toil; they feud, flirt, and swap genes. Viruses infecting bacteria and archaea are abundant even in the deep sea, lysing cells and recycling nutrients while shuttling genes between hosts. CRISPR spacer records in vent microbes bear the scars of repeated viral skirmishes, a molecular diary of who fought whom in the dark.
Protists and small metazoans graze on bacteria, shaping community structure and catalyzing turnover. Horizontal gene transfer spreads metabolic tricks—like new oxidases or transporters—quickly across lineages as conditions shift. Biofilms on chimneys and carbonates become social hubs where cooperation and competition play out, with chemical gradients acting as the ever-dramatic plot twists driving evolution.
Perks for People: Enzymes, Materials, and Ideas Borrowed from the Deep

Biotech raided the vent pantry early. Thermostable DNA polymerases from hyperthermophiles—like Pfu from Pyrococcus furiosus and “Vent” polymerase from Thermococcus litoralis—power high-fidelity PCR and DNA assembly at lab benches worldwide. Enzymes that shrug off heat, pressure, and solvents inspire industrial catalysts for biofuels, pharmaceuticals, and green chemistry where ordinary proteins would unravel.
Materials and energy research piggyback on geology-meets-biology.
Metal sulfide chimneys prompt designs for electrocatalysts that reduce CO2 or split water more efficiently. Ideas from vent geochemistry inform origin-of-life experiments, while seep-derived carbonates and microbial corrosion studies guide infrastructure planning. Even if we never live by a black smoker, products and principles from sunless worlds are already mingling with everyday technology.
Handle With Care: Mining, Warming Seas, and Other Threats to Sunless Worlds

Deep-sea mining proposals target seafloor massive sulfide deposits at vents and polymetallic nodules on abyssal plains. Disturbance plumes, noise, and habitat removal could erase communities that assemble over decades to millennia. Scientists and conservation groups have called for precaution—up to and including moratoria—while ecological baselines and recovery prospects are assessed, because many of these habitats are rare and poorly mapped.
Climate change adds pressure.
Warming, deoxygenation, and acidification alter the chemistry that chemosynthetic life depends on, shifting redox balances and carbonate stability. Oil and gas extraction at seeps brings spill risks and physical disruption. Safeguards—marine protected areas, careful permitting, and long-term monitoring—buy time to understand these systems before we remodel them. In the dark, unintended consequences can be hard to see until they’re irreversible.




